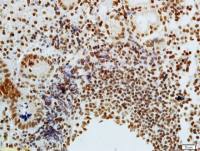
phospho-CDKN1A/p21 (Thr57) antibody

相关产品推荐更多 >
万千商家帮你免费找货
0 人在求购买到急需产品
- 详细信息
- 技术资料
- 形态:
粉末/液体
- 保存条件:
-20℃至-80℃
- 克隆性:
见说明书
- 标记物:
未标记
- 适应物种:
Homo sapiens (Hukl)
- 宿主:
Mouse小鼠,Human人,Rat大鼠、、、、、
- 应用范围:
WB, ICC, IHC-P, IHC-F, ELISA
- 浓度:
500ug/ml
- 抗体英文名:
Monoclonal Antibody to Toll Like Receptor 5 (TLR5)
- 抗体名:
Toll样受体5(TLR5)单克隆抗体
- 规格:
200ug
单克隆抗体的制备
www.klbscience.com
自Kohler和Milstein建立了淋巴细胞杂交瘤技术后,他们将只针对一种抗原决定簇产生抗体B淋巴细胞和能无限增殖的肿瘤细胞融合杂交,产生既能分泌抗体,又能无限增殖的杂交融合细胞,它所产生的抗体是针对同一抗原决定簇的高度同质的抗体,即单克隆抗体(monoclonal antibody),简称单抗。与多抗相比,单抗纯度高,专一性强、重复性好、且能持续地无限量供应。单抗技术的问世,不仅带来了免疫学领域里的一次革命,而且它在生物医学科学的各个领域获得极广泛的应用,促进了众多学科的发展。www.klbscience.com
单克隆抗体制备的基本过程如下:
(1)用抗原免疫小鼠;
(2)从抗原免疫过的小鼠获取脾细胞;
(3)应用细胞杂交技术使骨髓瘤细胞与B淋巴细胞融合,得到杂交瘤细胞。这种细胞不仅能够像B淋巴细胞一样合成性质稳定的转移性抗体,而且能够像骨髓瘤细胞一样无限复制,这样就可以产生大量且性质专一的鼠源抗体;
(4)对获得的杂交瘤细胞进行筛选,选出能分泌高效价抗体的杂交瘤;
(5)对已筛选出的单个细胞进行鉴定和克隆。
杂交瘤产生的单克隆抗体在各个领域中应用越来越广,有很大的优点和潜力。能够根据需要进行研发生产,可建立稳定的细胞株持续供给应用,相比于抗血清能够减少大量的动物和费用,而且纯度高,均一性好,可作为一种标准试剂。
在获得能分泌高效价抗体的杂交瘤细胞株后,一般有两种方法来获得单克隆抗体:小鼠腹腔注射杂交瘤细胞和细胞培养。
(1)小鼠腹水:
将杂交瘤细胞接种到小鼠的腹腔,杂交瘤在腹腔内增殖,取得腹水进行纯化即可得到抗体。此法易于操作,重复性高,且花费少,得到的抗体量多,但伤害动物,而且当需要大规模制备抗体时需要大量动物。
(2)细胞培养:
将杂交瘤细胞进行培养,培养后的上清液中即含有抗体。这种方法适合大规模生产抗体。但是这种方法获得的抗体杂质相对较多,因为细胞上清含有培养液,pH指示剂,细胞代谢废物等。而且培养用的血清中的成分不明确,可能会含有能影响抗体纯度的杂蛋白。所以在细胞培养中会逐渐将杂交瘤细胞通过逐步减少血清来驯化到无血清培养。
总之,单克隆抗体的高特异性,重复性使其在生物研究以及医药方向都有良好的应用基础以及前景。
免疫组织化学常见问题和解决方法
www.klbscience.com
免疫组织化学技术又称免疫细胞化学技术,是指用标记的特异性抗体在组织细胞原位通过抗原抗体反应和组织化学的呈色反应,对相应抗原进行定性、定位、定量测定的一项免疫检测方法。它把免疫反应的特异性、组织化学的可见性和分子生物技术的敏感性等巧妙结合,借助显微镜的显像和放大作用,在细胞、亚细胞水平检测各种抗原物质(如蛋白质、多肽、酶、激素、病原体以及受体等),是单一的静止的形态学描述,上升到结构、功能和代谢为一体的动态观察,为疾病的诊断、鉴别诊断和发病机制的研究提供了强有力的手段。www.klbscience.com
然而,要想得到一张高质量的免疫组化染色切片也并非易事。由于切片制作和免疫组化染色过程均存在很多步骤或环节,每一个步骤或环节都需要操作者严格控制实验条件,否则可能会影响到最终结果。
风险提示:丁香通仅作为第三方平台,为商家信息发布提供平台空间。用户咨询产品时请注意保护个人信息及财产安全,合理判断,谨慎选购商品,商家和用户对交易行为负责。对于医疗器械类产品,请先查证核实企业经营资质和医疗器械产品注册证情况。
技术资料暂无技术资料 索取技术资料
Toll样受体5(TLR5)单克隆抗体
询价